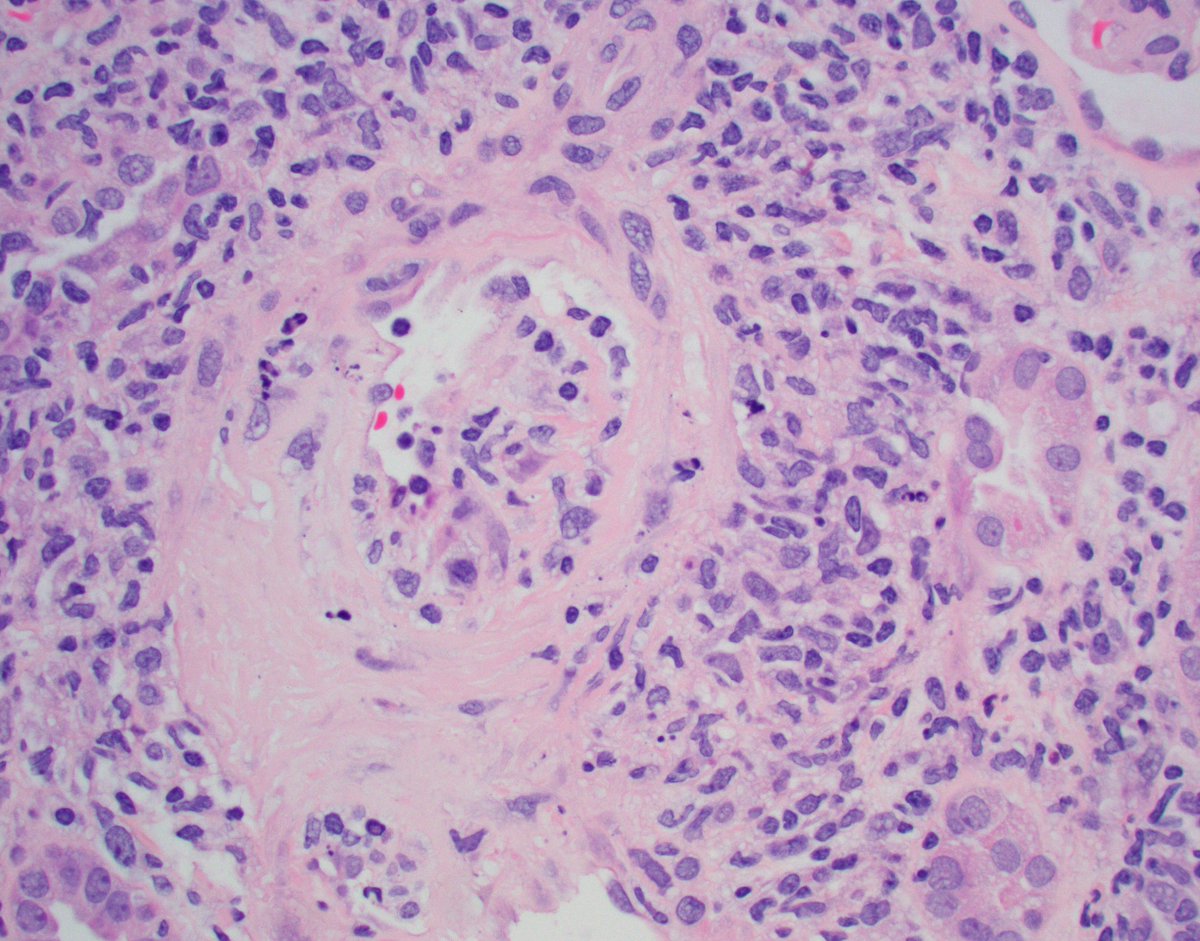
Jonathan Zuckerman MD PhD tweet media

Sabitlenmiş Tweet

Mini case-series of crystal-storing histiocytosis (CSH) affecting predominantly glomerular loops with detailed literature review of renal CSH, images of one of the cases are depicted below, authors.elsevier.com/c/1Zh4S3uV~y8B…
@raghupillappa, @JZRenalPath, @CArnold_GI




English